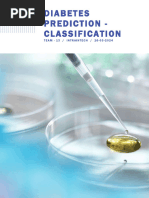

0% found this document useful (0 votes)
33 views20 pagesDiabetes Prediction Using Machine Learning
The document discusses the development of a predictive model for diabetes classification, highlighting the need for accurate early detection and management of the disease. It details the methodology, including data cleaning, exploratory data analysis, and model training using various algorithms such as Logistic Regression, Naive Bayes, KNN, Random Forest, and XGBoost. The results indicate that the Random Forest model achieved the highest accuracy of 89.44%, outperforming other models in predicting diabetes.
Uploaded by
mazinaCopyright
© © All Rights Reserved
We take content rights seriously. If you suspect this is your content, claim it here.
Available Formats
Download as PDF, TXT or read online on Scribd
0% found this document useful (0 votes)
33 views20 pagesDiabetes Prediction Using Machine Learning
The document discusses the development of a predictive model for diabetes classification, highlighting the need for accurate early detection and management of the disease. It details the methodology, including data cleaning, exploratory data analysis, and model training using various algorithms such as Logistic Regression, Naive Bayes, KNN, Random Forest, and XGBoost. The results indicate that the Random Forest model achieved the highest accuracy of 89.44%, outperforming other models in predicting diabetes.
Uploaded by
mazinaCopyright
© © All Rights Reserved
We take content rights seriously. If you suspect this is your content, claim it here.
Available Formats
Download as PDF, TXT or read online on Scribd
/ 20